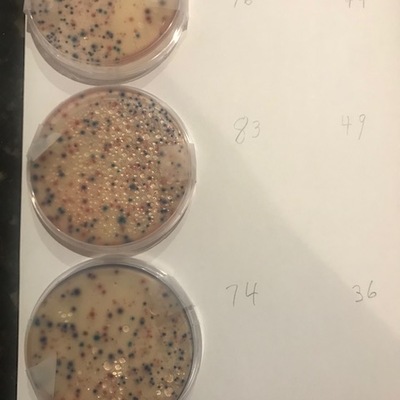

Organization
FRACA
Dataset summary
-
1 Datasets
- 6 Locations
- 3,083 Datapoints
- 3 Contributors
-
Datasets
- Located at 5401 Fowl River Rd, Theodore, AL United States 36582,
- Email jenzimlich@gmail.com
- Website https://www.facebook.com/pages/Fowl-River-Community-Center/202024936490886
Latest contribution
 Theodore F. Henken
on 20 March at Off the dock for 4221 Lewis Loop Road South Theodore, Al 36582
Theodore F. Henken
on 20 March at Off the dock for 4221 Lewis Loop Road South Theodore, Al 36582